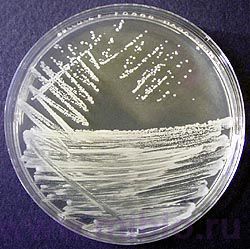

Полезное:
Как сделать разговор полезным и приятным
Как сделать объемную звезду своими руками
Как сделать то, что делать не хочется?
Как сделать погремушку
Как сделать так чтобы женщины сами знакомились с вами
Как сделать идею коммерческой
Как сделать хорошую растяжку ног?
Как сделать наш разум здоровым?
Как сделать, чтобы люди обманывали меньше
Вопрос 4. Как сделать так, чтобы вас уважали и ценили?
Как сделать лучше себе и другим людям
Как сделать свидание интересным?

Категории:
АрхитектураАстрономияБиологияГеографияГеологияИнформатикаИскусствоИсторияКулинарияКультураМаркетингМатематикаМедицинаМенеджментОхрана трудаПравоПроизводствоПсихологияРелигияСоциологияСпортТехникаФизикаФилософияХимияЭкологияЭкономикаЭлектроника

Культуральні ознаки дріжджів
|
|
Культуральні ознаки – характеризують ріст культури в рідких або на щільних середовищах. Культуральні ознаки дуже мінливі і сильно залежать від складу середовища і умов культивування, тому вони мають досить обмежене значення в систематиці дріжджів. Тим не менш, багато видів дріжджів істотно відрізняються за характером росту на скошеному агарі або у вигляді гігантської колонії, що на практиці дає можливість їх швидкої ідентифікації. До культуральних ознак відносять характер росту мікроорганізмів на рідких та твердих поживних середовищах.[4]
У хлібопеченні використовуються верхові дріжджі. При зростанні на рідкому поживному середовищі вони викликають її помутніння. У результаті інтенсивного газоутворення клітини дріжджів виносяться у верхні шари рідині, що бродить, а на поверхні утворюється піна. Після закінчення бродіння середовище стає більш прозорим, дріжджі осідають на дно, утворюючи щільний осад жовтувато-білого кольору. Плівка на поверхні середовища не розвивається.[8]
На поверхні щільного поживного середовища мікроорганізми можуть рости у вигляді окремих колоній, суцільно за штрихом та суцільним газоном.
Штрих на косому сусло-агарі опуклий, з рівними краями, соковитою консистенцією, жовтувато-білого кольору, маслянистий.
На сусло-агарі формуються колонії круглої форми діаметром 0,5-1 см з опуклим центром і рівними краями жовтувато-білого кольору. За характером поверхні описано два типи колоній Saccharomyces cerevisiae: гладкі, маслянисті і тваринний шорсткі, горбисті. На думку багатьох дослідників, культури дріжджів, що мають колонії другого типу, відрізняються зниженою бродильною активністю.
З’ясування систематичного положення мікроорганізмів це досить складна та клопітка задача, яка включає вивчення цілої сукупності ознак: морфології клітин, характеру росту на різних поживних середовищах, способів отримання енергії, потреб у певних сполуках для конструктивного обміну та ін. Проте, в деяких випадках, достатнім виявляється визначення лише окремих ознак. До таких ознак можуть бути віднесені макроморфологічні (культуральні) особливості та форма клітин бактерій [1].
Рис.1.7. Ріст дріжджів на поверхні щільного поживного середовища
Date: 2015-07-22; view: 2785; Нарушение авторских прав